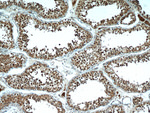
PLK5 Antibody in Immunohistochemistry (Paraffin) (IHC (P))

Search
Proteintech
PLK5 Polyclonal Antibody
{{$productOrderCtrl.translations['antibody.pdp.commerceCard.promotion.promotions']}}
{{$productOrderCtrl.translations['antibody.pdp.commerceCard.promotion.viewpromo']}}
{{$productOrderCtrl.translations['antibody.pdp.commerceCard.promotion.promocode']}}: {{promo.promoCode}} {{promo.promoTitle}} {{promo.promoDescription}}. {{$productOrderCtrl.translations['antibody.pdp.commerceCard.promotion.learnmore']}}
产品信息
21299-1-AP
种属反应
宿主/亚型
分类
类型
抗原
偶联物
形式
浓度
规格
纯化类型
保存液
内含物
保存条件
运输条件
产品详细信息
This antibody detects both PLK5 gene of human and mouse.
Immunogen sequence: MYTVLTGTP PFMASPLSEM YQNIREGHYP EPAHLSANAR RLIVHLLAPN PAERPSLDHL LQDDFFTQGF TPDRLPAHSC HSPPIFAIPP PLGRIFRKVG QRLLTQCRPP CPFTPKEASG PGEGGPDPDS MEWDGESSLS AKEVPCLEGP IHLVAQGTLQ SDLAGPEGSR RPEVEAALRH LQLCLDVGPP ATQDPLGEQQ PILWAPKWVD YSSKYGFGYQ LLDGGRTGRH PHGPATPRRE GTLPTPVPPA GPGLCLLRFL ASEHALLLLF SNGMVQVSFS GVPAQLVLSG EGEGLQLTLW EQGSPGTSYS LDVPQSHGCA PTTGQHLHHA LRMLQSI (1-336 aa encoded by BC100792)
靶标信息
Polo-like kinase 5 (PLK5) is a member of the Polo-like kinase family, notable for its involvement in cell cycle regulation processes such as mitotic entry, spindle formation, and cytoplasmic division. PLK5 is distinguished from other family members by its low expression levels, particularly within different immunophenotypes, except for being notably elevated in the C5 subtype. Its expression has been linked to poor prognosis in non-small cell lung cancer, although this is not universally supported by all data sources, suggesting complex roles in tumor biology. In a mouse model, PLK5 functions as a DNA damage-inducible gene with nucleolar localization, facilitated by a specific nucleolus localization signal in its N-terminal. The protein's ectopic expression can lead to G1 phase arrest, indicating its role in cellular response to DNA damage. Research is ongoing to fully elucidate its function and prognostic implications across various cancer types.
仅用于科研。不用于诊断过程。未经明确授权不得转售。
生物信息学
蛋白别名: Inactive serine/threonine-protein kinase PLK5; PLK-5; plk5; Polo-like kinase 5; polo-like kinase 5, pseudogene; serine/threonine-protein kinase PLK5; unnamed protein product
基因别名: 6330514A18Rik; FG060302; PLK-5; PLK5; PLK5P; SgK384ps
UniProt ID: (Human) Q496M5, (Mouse) Q4FZD7
Entrez Gene ID: (Human) 126520, (Mouse) 216166